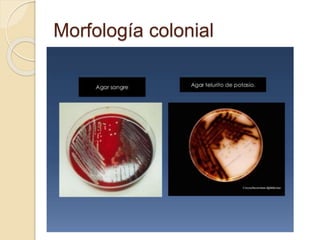
Morfología colonial
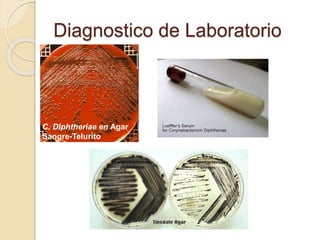
Diagnostico de Laboratorio
C. Diphtheriae en Agar
Sangre-Telurito

Este documento describe a Corynebacterium diphtheriae, la bacteria causante de la difteria. Se detallan sus características morfológicas, factores de virulencia como la toxina diftérica, patogenia, diagnóstico de laboratorio y medidas de prevención. También presenta un caso clínico de una paciente con aislamiento de C. diphtheriae no toxigénico en Puebla, México.